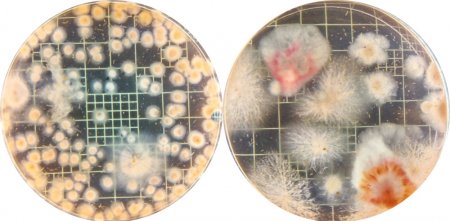

Una investigación de la FAUBA detectó que un hongo de suelo benéfico es una potente alternativa en el manejo y control de Fusarium.
El hongo Fusarium pseudograminearum, vulgarmente conocido como Fusarium, es una enfermedad muy dañina para el cultivo de trigo, que es muy difícil de erradicar porque sus propágulos quedan en el suelo y en los restos de los cultivos anteriores, infectando al siguiente.
Sin embargo, algo comenzó a cambiar, de acuerdo a lo que publica la revista de divulgación científica “Sobre La Tierra”.
Una primera investigación demostró que se redujo un 20% la cantidad de plantas enfermas por efecto de Fusarium, gracias a la acción de un hongo micorrícico benéfico de suelo.
De acuerdo al trabajo de Federico Spagnoletti, docente de Microbiología Agrícola en la Facultad de Agronomía (UBA), se evaluó la eficacia Rhizophagus intraradices, el benéfico, que establece una relación de simbiosis con el cultivo.
“Nuestros resultados muestran que el hongo ‘benéfico’ redujo el efecto de la infección en un 76%, con lo cual mejoró la condición de las plantas enfermas y que se perdieron del stand de plantas. Además, se aclaró el color de las raíces”, dice Spagnoletti.
Por otro lado, también hubo efectos preventivos. En el estudio, el investigador comprobó que la presencia de R. intraradices redujo la cantidad de plantas afectadas por la enfermedad, con respecto a las que no lo tenían.
“Este es el primer trabajo publicado que muestra la efectividad del uso de R. intraradices para controlar la podredumbre de las raíces que causa Fusarium”, sostiene el experto, que también es investigador de CONICET y su trabajo fue publicado en la revista “Rhizosphere”.
“Hoy, la enfermedad que causa F. pseudograminearum se controla con fungicidas, aunque la efectividad de este manejo está discutida. Otra alternativa es rotar los cultivos, usando plantas que no sean susceptibles a la infección de este patógeno, como el sorgo, o cultivos que no sean gramíneas, como la colza o el garbanzo. Y también se debe tener en cuenta el manejo de las malezas que sean gramíneas, ya que pueden ser reservorios del hongo”, afirmó Spagnoletti.